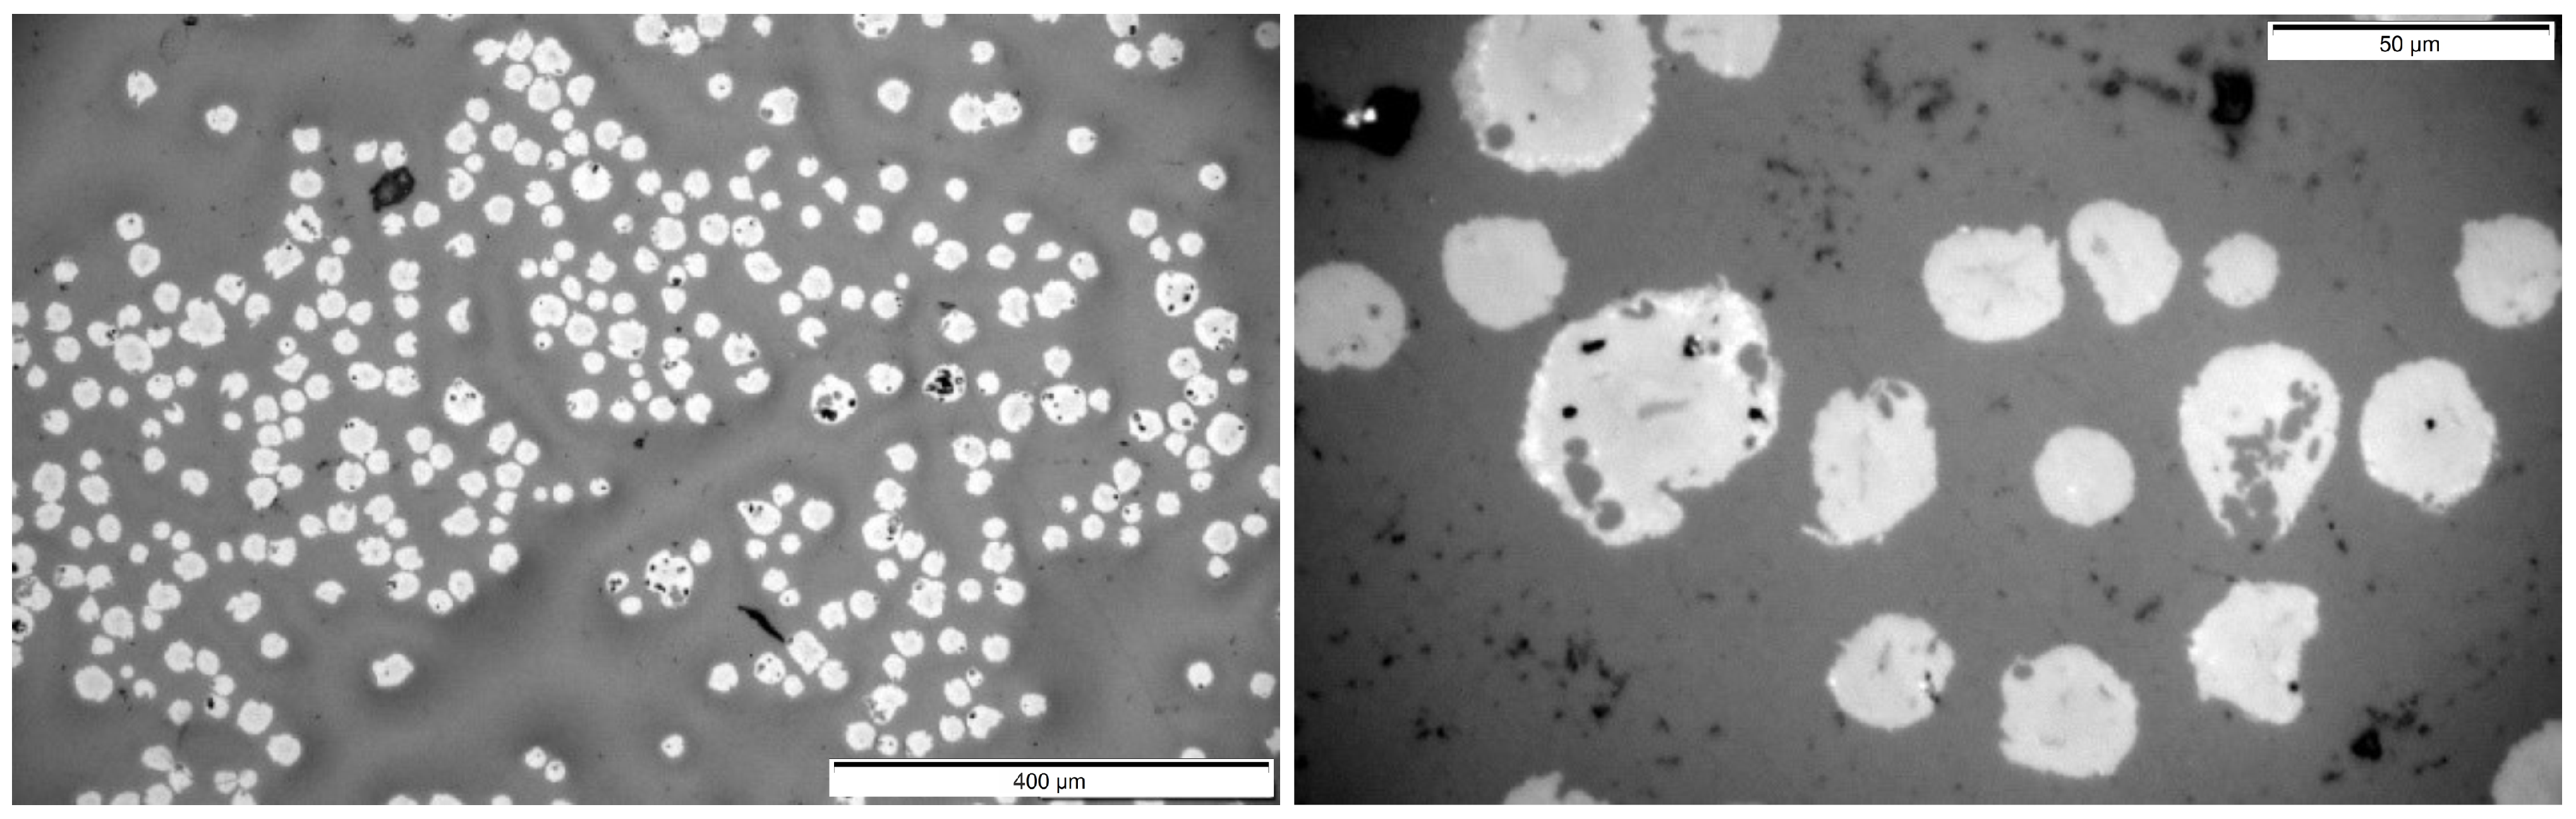
Fibers 12 00050 g0a1

Potentials of Polyacrylonitrile Substitution by Lignin for Continuous Manufactured Lignin/Polyacrylonitrile-Blend-Based Carbon Fibers
Abstract
1. Introduction
2. Materials and Methods
2.1. Materials
2.2. Precursor Fiber Spinning
2.3. Thermal Conversion
2.4. Characterization
3. Results and Discussion
Influence of Lignin Contents
4. Conclusions
Author Contributions
Funding
Data Availability Statement
Acknowledgments
Conflicts of Interest
Abbreviations
| AcL | Acetylated lignin |
| LS | Lignosulfonate |
| AcLi/LSi | Samples with weight percentage i of AcL resp. LS |
| CFs | Carbon fibers |
| DIN | German institute for standards |
| DMSO | Dimethyl sulfoxide |
| DMF | Dimethylformamide |
| DSC | Differential scanning calorimetry |
| DOAJ | Directory of open access journals |
| HZi | Heating zone i |
| MDPI | Multidisciplinary Digital Publishing Institute |
| PAN | Polyacrylonitrile |
| PF | Precursor fiber |
| SI | Stabilization index |
| TGA | Thermogravimetrical analysis |
| DTG | Derivative Thermogravimetry |
| SD | Standard deviation |
Appendix A

| Label | Lig | [m] | [m] | [MPa] | [MPa] | E [GPa] | [GPa] | [%] | [%] | |
|---|---|---|---|---|---|---|---|---|---|---|
| - | 7.89 | 0.58 | 2379 | 379 | 207 | 9 | 1.19 | 0.19 | ||
| 1 | LS | 8.33 | 0.60 | 2062 | 332 | 175 | 14 | 1.25 | 0.17 | |
| 2 | LS | 8.43 | 0.85 | 1880 | 295 | 188 | 22 | 1.04 | 0.14 | |
| 10 | LS | 7.91 | 0.99 | 2242 | 311 | 216 | 15 | 1.09 | 0.13 | |
| 15 | LS | 8.54 | 1.22 | 1209 | 296 | 181 | 14 | 0.69 | 0.14 | |
| 1 | AcL | 8.16 | 1.02 | 2428 | 271 | 196 | 13 | 1.33 | 0.13 | |
| 2 | AcL | 8.85 | 0.89 | 2073 | 226 | 172 | 12 | 1.28 | 0.14 | |
| 5 | AcL | 8.14 | 1.06 | 2389 | 299 | 189 | 15 | 1.34 | 0.14 | |
| 10 | AcL | 7.50 | 1.48 | 2466 | 425 | 200 | 28 | 1.31 | 0.12 | |
| 10 | AcL | 8.20 | 1.09 | 2360 | 362 | 183 | 22 | 1.36 | 0.14 |

| Label | Gamma Distribution of | Gamma Distribution Parameters of E | ||
|---|---|---|---|---|
| Parameter | ||||
| 37.4 | 63.5 | 561 | 0.34 | |
| 37.6 | 54.8 | 157 | 1.12 | |
| 40.6 | 46.3 | 75.8 | 2.50 | |
| 53.2 | 42.1 | 214 | 1.00 | |
| 15.3 | 79.0 | 170 | 1.07 | |
| 78.2 | 31.0 | 254 | 0.77 | |
| 82.7 | 25.1 | 200 | 0.86 | |
| 65.2 | 36.6 | 147 | 1.29 | |
| 35.8 | 68.9 | 51.5 | 3.89 | |

References
- Choi, D.; Kil, H.-S.; Lee, S. Fabrication of Low-Cost Carbon Fibers Using Economical Precursors and Advanced Processing Technologies. Carbon 2019, 142, 610–649. [Google Scholar] [CrossRef]
- Jäger, H.; Cherif, C.; Kirsten, M.; Behnisch, T.; Wolz, D.S.; Böhm, R.; Gude, M. Influence of Processing Parameters on the Properties of Carbon Fibers—An Overview. Mater. Werkst. 2016, 47, 1044–1057. [Google Scholar] [CrossRef]
- Böhm, R.; Thieme, M.; Wohlfahrt, D.; Wolz, D.S.; Richter, B.; Jäger, H. Reinforcement Systems for Carbon Concrete Composites Based on Low-Cost Carbon Fibres. Fibers 2018, 6, 56. [Google Scholar] [CrossRef]
- Wang, S.; Bai, J.; Innocent, M.T.; Wang, Q.; Xiang, H.; Tang, J.; Zhu, M. Lignin-Based Carbon Fibers: Formation, Modification and Potential Applications. Green Energy Environ. 2022, 7, 578–605. [Google Scholar] [CrossRef]
- Baker, D.A.; Rials, T.G. Recent Advances in Low-Cost Carbon Fibre Manufacture from Lignin. J. Appl. Polym. Sci. 2013, 130, 713–728. [Google Scholar] [CrossRef]
- Qu, W.; Yang, J.; Sun, X.; Bai, X.; Jin, H.; Zhang, M. Towards Producing High-Quality Lignin-Based Carbon Fibers: A Review of Crucial Factors Affecting Lignin Properties and Conversion Techniques. Int. J. Biol. Macromol. 2021, 189, 768–784. [Google Scholar] [CrossRef] [PubMed]
- Ogale, A.A.; Zhang, M.; Jin, J. Recent advances in carbon fibres derived from biobased precursors. J. Appl. Polym. Sci. 2016, 133, 43794. [Google Scholar] [CrossRef]
- Sagues, W.J.; Jain, A.; Brown, D.; Aggarwal, S.; Suarez, A.; Kollman, M.; Park, S.; Argyropoulos, D.S. Are Lignin-Derived Carbon Fibers Graphitic Enough? Green Chem. 2019, 21, 4253–4265. [Google Scholar] [CrossRef]
- Mack, D.; Berthold, L.-S.; Traa, Y.; Klemm, E. New Two-Step Pathway for the Production of Acrylonitrile from Propionic Acid. Catal. Commun. 2020, 136, 105891. [Google Scholar] [CrossRef]
- Mack, D.; Schätzle, S.; Traa, Y.; Klemm, E. Synthesis of Acrylonitrile from Renewable Lactic Acid. ChemSusChem 2019, 12, 1653–1663. [Google Scholar] [CrossRef]
- Arnold, U.; Brück, T.; De Palmenaer, A.; Kuse, K. Carbon Capture and Sustainable Utilization by Algal Polyacrylonitrile Fiber Production: Process Design, Techno-Economic Analysis, and Climate Related Aspects. Ind. Eng. Chem. Res. 2018, 57, 7922–7933. [Google Scholar] [CrossRef]
- Song, L.; Ouyang, Q.; Huang, X.; Ma, H.; Chen, P.; Shen, L.; Wang, X. Carbon Fibers with Low Cost and Uniform Disordered Structure Derived from Lignin/Polyacrylonitrile Composite Precursors. Fibers Polym. 2021, 22, 240–248. [Google Scholar] [CrossRef]
- Zhang, B.; Lu, C.; Liu, Y.; Yuan, S. Wet Spun Polyacrylonitrile-Based Hollow-Mesoporous Carbon Fiber: Stabilization, Carbonization and Its Basic Properties. Polym. Degrad. Stab. 2019, 170, 109021. [Google Scholar] [CrossRef]
- Liu, H.C.; Luo, J.; Chang, H.; Bakhtiary Davijani, A.A.; Wang, P.-H.; Kumar, S. Polyacrylonitrile Sheath and Polyacrylonitrile/Lignin Core Bi-Component Carbon Fibers. Carbon 2019, 149, 165–172. [Google Scholar] [CrossRef]
- Liu, H.; Dai, Z.; Cao, Q.; Shi, X.; Wang, X.; Li, H.; Han, Y.; Li, Y.; Zhou, J. Lignin/Polyacrylonitrile Carbon Fibers: The Effect of Fractionation and Purification on Properties of Derived Carbon Fibers. ACS Sustain. Chem. Eng. 2018, 6, 8554–8562. [Google Scholar] [CrossRef]
- Liu, D.; Ouyang, Q.; Jiang, X.; Ma, H.; Chen, Y.; He, L. Thermal Properties and Thermal Stabilization of Lignosulfonate-Acrylonitrile-Itaconic Acid Terpolymer for Preparation of Carbon Fiber. Polym. Degrad. Stab. 2018, 150, 57–66. [Google Scholar] [CrossRef]
- Jin, J.; Ogale, A.A. Carbon Fibers Derived from Wet-Spinning of Equi-Component Lignin/Polyacrylonitrile Blends. J. Appl. Polym. Sci. 2018, 135, 45903. [Google Scholar] [CrossRef]
- Jin, J.; Ding, J.; Klett, A.; Thies, M.C.; Ogale, A.A. Carbon Fibers Derived from Fractionated–Solvated Lignin Precursors for Enhanced Mechanical Performance. ACS Sustain. Chem. Eng. 2018, 6, 14135–14142. [Google Scholar] [CrossRef]
- Maradur, S.P.; Kim, C.H.; Kim, S.Y.; Kim, B.-H.; Kim, W.C.; Yang, K.S. Preparation of Carbon Fibers from a Lignin Copolymer with Polyacrylonitrile. Synth. Met. 2012, 162, 453–459. [Google Scholar] [CrossRef]
- Jiang, X.; Ouyang, Q.; Liu, D.; Huang, J.; Ma, H.; Chen, Y.; Wang, X.; Sun, W. Preparation of low-cost carbon fibre precursors from blends of wheat straw lignin and commercial textile-grade polyacrylonitrile (PAN). Wood Res. Technol. 2018, 72, 727–734. [Google Scholar]
- Liu, H.C.; Chien, A.-T.; Newcomb, B.A.; Liu, Y.; Kumar, S. Processing, Structure, and Properties of Lignin- and CNT-Incorporated Polyacrylonitrile-Based Carbon Fibers. ACS Sustain. Chem. Eng. 2015, 3, 1943–1954. [Google Scholar] [CrossRef]
- Xia, K.; Ouyang, Q.; Chen, Y.; Wang, X.; Qian, X.; Wang, L. Preparation and Characterization of Lignosulfonate–Acrylonitrile Copolymer as a Novel Carbon Fiber Precursor. ACS Sustain. Chem. Eng. 2016, 4, 159–168. [Google Scholar] [CrossRef]
- Dér, A.; Dilger, N.; Kaluza, A.; Creighton, C.; Kara, S.; Varley, R.; Herrmann, C.; Thiede, S. Modelling and Analysis of the Energy Intensity in Polyacrylonitrile (PAN) Precursor and Carbon Fibre Manufacturing. J. Clean. Prod. 2021, 303, 127105. [Google Scholar] [CrossRef]
- Groetsch, T.; Maghe, M.; Rana, R.; Hess, R.; Nunna, S.; Herron, J.; Buckmaster, D.; Creighton, C.; Varley, R.J. Gas Emission Study of the Polyacrylonitrile-Based Continuous Pilot-Scale Carbon Fiber Manufacturing Process. Ind. Eng. Chem. Res. 2021, 60, 17379–17389. [Google Scholar] [CrossRef]
- Groetsch, T.; Creighton, C.; Varley, R.; Kaluza, A.; Dér, A.; Cerdas, F.; Herrmann, C. A Modular LCA/LCC-Modelling Concept for Evaluating Material and Process Innovations in Carbon Fibre Manufacturing. Procedia CIRP 2021, 98, 529–534. [Google Scholar] [CrossRef]
- Dong, X.; Lu, C.; Zhou, P.; Zhang, S.; Wang, L.; Li, D. Polyacrylonitrile/lignin sulfonate blend fibre for low-cost carbon fibre. RSC Adv. 2015, 5, 42259–42265. Available online: https://pubs.rsc.org/en/content/articlelanding/2015/ra/c5ra01241d#!divAbstract (accessed on 13 August 2023). [CrossRef]
- Porkodi, P.; Abhilash, J.K.; Shukla, H.K. On the Structural Changes, Mechanism and Kinetics of Stabilization of Lignin Blended Polyacrylonitrile Copolymer Fiber. J. Polym. Res. 2022, 29, 436. [Google Scholar] [CrossRef]
- Kirsten, M.; Meinl, J.; Schönfeld, K.; Michaelis, A.; Cherif, C. Characteristics of wet-spun and thermally treated poly acrylo-nitrile fibres. J. Appl. Polym. Sci. 2016, 133, 43698. [Google Scholar] [CrossRef]
- Gohs, U.; Böhm, R.; Brünig, H.; Fischer, D.; Häussler, L.; Kirsten, M.; Malanin, M.; Müller, M.-T.; Cherif, C.; Wolz, D.S.J.; et al. Electron beam treatment of polyacrylonitrile copolymer above the glass transition temperature in air and nitrogen at-mosphere. Radiat. Phys. Chem. 2019, 156, 22–30. [Google Scholar] [CrossRef]
- Gohs, U.; Böhm, R.; Brünig, H.; Fischer, D.; Leopold, A.-K.; Malanin, M.; Müller, M.-T.; Cherif, C.; Richter, M.; Wolz, D.S.J.; et al. Influence of gas atmosphere on electron-induced reactions of polyacrylonitrile homopolymer powder at elevated temperature. Radiat. Phys. Chem. 2019, 158, 94–102. [Google Scholar] [CrossRef]
- Kirsten, M.; Freudenberg, C.; Cherif, C. Carbonfasern—Der Werkstoff des 21. Jahrhunderts. Beton- Stahlbetonbau 2015, 110, 8–15. [Google Scholar] [CrossRef]
- Sadeghi Bogar, M.; Wolf, J.; Wolz, D.S.J.; Seidel-Greiff, R.; Dmitrieva, E.; Israel, N.; Rosenkranz, M.; Behnisch, T.; Müller, M.T.; Gude, M. Sensitivity of Offline and Inline Indicators for Fiber Stretching in Continuous Polyacrylonitrile Stabilization. Fibers 2023, 11, 68. [Google Scholar] [CrossRef]
- Byrne, N.; De Silva, R.; Ma, Y.; Sixta, H.; Hummel, M. Enhanced stabilization of cellulose-lignin hybrid filaments for carbon fiber production. Cellulose 2018, 25, 723–733. [Google Scholar] [CrossRef] [PubMed]
- DIN 65569-2:1992-10; Aerospace; Reinforcement Fibres; Determination of Density of Filament Yarns; Hydrostatic Weighing Method. German Institute for Standardisation: Berlin, Germany, 1992. Available online: https://www.beuth.de/de/norm/din-65569-2/1944125 (accessed on 5 May 2023).
- Tsai, J.-S.; Hsu, H.-N. Determination of the Aromatization Index for Oxidized Polyacrylonitrile Fibre by the Differential Scanning Calorimetry Method. J. Mater. Sci. Lett. 1992, 11, 1403–1405. [Google Scholar] [CrossRef]
- Takaku, A.; Hashimoto, T.; Miyoshi, T. Tensile Properties of Carbon Fibers from Acrylic Fibers Stabilized under Isothermal Conditions. J. Appl. Polym. Sci. 1985, 30, 1565–1571. [Google Scholar] [CrossRef]
- Fitzer, E.; Frohs, W.; Heine, M. Optimization of Stabilization and Carbonization Treatment of PAN Fibres and Structural Characterization of the Resulting Carbon Fibres. Carbon 1986, 24, 387–395. [Google Scholar] [CrossRef]
- Ding, R.; Wu, H.; Thunga, M.; Bowler, N.; Kessler, M.R. Processing and Characterization of Low-Cost Electrospun Carbon Fibers from Organosolv Lignin/Polyacrylonitrile Blends. Carbon 2016, 100, 126–136. [Google Scholar] [CrossRef]
- Attwenger, A. Value-Added Lignin Based Carbon Fiber from Organosolv Fractionation of Poplar and Switchgrass. Master’s Thesis, University of Tennessee, Knoxville, TN, USA, 2014. Available online: http://trace.tennessee.edu/utk_gradthes/2768 (accessed on 7 December 2022).
- Baker, D.A.; Baker, F.S.; Gallego, N.C. Thermal Engineering of Lignin for Low-Cost Production of Carbon Fiber. In Proceedings of the The Fiber Society 2009 Fall Meeting and Technical Conference, Athens, GA, USA, 28–30 October 2009. [Google Scholar]
- Baker, D.A.; Gallego, N.C.; Baker, F.S. On the Characterization and Spinning of an Organic-Purified Lignin toward the Manufacture of Low-Cost Carbon Fiber. J. Appl. Polym. Sci. 2012, 124, 227–234. [Google Scholar] [CrossRef]
- Eberle, C. R&D on Low—Cost Carbon Fiber Composites for Energy Applications. Carbon Fiber RD Workshop 2017, 25. [Google Scholar]
- Hosseinaei, O.; Harper, D.P.; Bozell, J.J.; Rials, T.G. Improving Processing and Performance of Pure Lignin Carbon Fibers through Hardwood and Herbaceous Lignin Blends. Int. J. Mol. Sci. 2017, 18, 1410. [Google Scholar] [CrossRef]
- Hosseinaei, O.; Harper, D.P.; Bozell, J.J.; Rials, T.G. Role of Physicochemical Structure of Organosolv Hardwood and Herbaceous Lignins on Carbon Fiber Performance. ACS Sustain. Chem. Eng. 2016. [Google Scholar] [CrossRef]
- Kadla, J.F.; Kubo, S.; Venditti, R.A.; Gilbert, R.D.; Compere, A.L.; Griffith, W. Lignin-Based Carbon Fibers for Composite Fiber Applications. Carbon 2002, 40, 2913–2920. [Google Scholar] [CrossRef]
- Kleinhans, J. Evaluation of the Carbonization of Thermo-Stabilized Lignin Fibers into Carbon Fibers. Master’s Thesis, Universität Linköping, Linköping, Sweden, 2015. Available online: http://www.diva-portal.org/smash/get/diva2:846024/FULLTEXT01.pdf (accessed on 28 September 2016).
- Kubo, S.; Kadla, J.F. Lignin-Based Carbon Fibers: Effect of Synthetic Polymer Blending on Fiber Properties. J. Polym. Environ. 2005, 13, 97–105. [Google Scholar] [CrossRef]
- Nordström, Y.; Joffe, R.; Sjöholm, E. Mechanical Characterization and Application of Weibull Statistics to the Strength of Softwood Lignin-Based Carbon Fibers. J. Appl. Polym. Sci. 2013, 130, 3689–3697. [Google Scholar] [CrossRef]
- Qin, W.; Kadla, J.F. Carbon Fibers Based on Pyrolytic Lignin. J. Appl. Polym. Sci. 2012, 126, E204–E213. [Google Scholar] [CrossRef]
- Qu, W.; Xue, Y.; Gao, Y.; Rover, M.; Bai, X. Repolymerization of Pyrolytic Lignin for Producing Carbon Fiber with Improved Properties. Biomass Bioenergy 2016, 95, 19–26. [Google Scholar] [CrossRef]
- Qu, W.; Liu, J.; Xue, Y.; Wang, X.; Bai, X. Potential of Producing Carbon Fiber from Biorefinery Corn Stover Lignin with High Ash Content. J. Appl. Polym. Sci. 2018, 135, 45736. [Google Scholar] [CrossRef]
- Salmén, L.; Bergnor, E.; Olsson, A.-M.; Åkerström, M.; Uhlin, A. Extrusion of Softwood Kraft Lignins as Precursors for Carbon Fibres. BioResources 2015, 10, 7544–7554. [Google Scholar] [CrossRef]
- Sudo, K.; Shimizu, K. A New Carbon Fiber from Lignin. J. Appl. Polym. Sci. 1992, 44, 127–134. [Google Scholar] [CrossRef]
- Uraki, Y.; Kubo, S.; Nigo, N.; Sano, Y.; Sasaya, T. Preparation of Carbon Fibers from Organosolv Lignin Obtained by Aqueous Acetic Acid Pulping. Holzforsch. Int. J. Biol. Chem. Phys. Technol. Wood 1995, 49, 343–350. [Google Scholar] [CrossRef]
- Zhang, M.; Ogale, A.A. Carbon Fibers from Dry-Spinning of Acetylated Softwood Kraft Lignin. Carbon 2014, 69, 626–629. [Google Scholar] [CrossRef]
- Zhang, M.; Jin, J.; Ogale, A.A. Carbon Fibers from UV-Assisted Stabilization of Lignin-Based Precursors. Fibers 2015, 3, 184–196. [Google Scholar] [CrossRef]
- Zhang, M. Carbon Fibers Derived from Dry-Spinning of Modified Lignin Precursors. Ph.D. Thesis, Clemson University, Clemson, SC, USA, 2016. Available online: http://tigerprints.clemson.edu/all_dissertations/1616 (accessed on 8 May 2023).
- Wang, S.; Li, Y.; Xiang, H.; Zhou, Z.; Chang, T.; Zhu, M. Low Cost Carbon Fibers from Bio-Renewable Lignin/Poly(Lactic Acid) (PLA) Blends. Compos. Sci. Technol. 2015, 119, 20–25. [Google Scholar] [CrossRef]
- Kanhere, S.V.; Tindall, G.W.; Ogale, A.A.; Thies, M.C. Carbon Fibers Derived from Liquefied and Fractionated Poplar Lignins: The Effect of Molecular Weight. iScience 2022, 25, 105449. [Google Scholar] [CrossRef] [PubMed]
- Bostan, L.; Hosseinaei, O.; Fourn, R.; Herrmann, A.S. Upscaling of Lignin Precursor Melt Spinning by Bicomponent Spinning and Its Use for Carbon Fibre Production. Philos. Trans. R. Soc. 2021, 379, 2209. [Google Scholar] [CrossRef]
- Culebras, M.; Beaucamp, A.; Wang, Y.; Clauss, M.M.; Frank, E.; Collins, M.N. Biobased Structurally Compatible Polymer Blends Based on Lignin and Thermoplastic Elastomer Polyurethane as Carbon Fiber Precursors. ACS Sustain. Chem. Eng. 2018, 6, 8816–8825. [Google Scholar] [CrossRef]
- Geng, L.; Cai, Y.; Lu, L.; Zhang, Y.; Li, Y.; Chen, B.; Peng, X.-F. Highly Strong and Conductive Carbon Fibers Originated from Bioinspired Lignin/Nanocellulose Precursors Obtained by Flow-Assisted Alignment and In Situ Interfacial Complexation. ACS Sustain. Chem. Eng. 2021, 9, 2591–2599. [Google Scholar] [CrossRef]
- Lin, J.; Kubo, S.; Yamada, T.; Koda, K.; Uraki, Y. Chemical Thermostabilization for the Preparation of Carbon Fibers from Softwood Lignin. BioResources 2012, 7, 5634–5646. [Google Scholar] [CrossRef]
- Li, Q.; Hu, C.; Li, M.; Truong, P.; Li, J.; Lin, H.-S.; Naik, M.T.; Xiang, S.; Jackson, B.E.; Kuo, W.; et al. Enhancing the Multi-Functional Properties of Renewable Lignin Carbon Fibers via Defining the Structure–Property Relationship Using Different Biomass Feedstocks. Green Chem. 2021, 23, 3725–3739. [Google Scholar] [CrossRef]
- Dai, Z.; Shi, X.; Liu, H.; Li, H.; Han, Y.; Zhou, J. High-Strength Lignin-Based Carbon Fibers via a Low-Energy Method. RSC Adv. 2018, 8, 1218–1224. [Google Scholar] [CrossRef]
- Zhang, W.; Wang, M.; Liu, W.; Yang, C.; Wu, G. Higher Dose Rate Effect of 500-KeV EB Irradiation Favoring Free Radical Annealing and Pre-Oxidation of Polyacrylonitrile Fibers. Polym. Degrad. Stab. 2019, 167, 201–209. [Google Scholar] [CrossRef]
- Ouyang, Q.; Xia, K.; Liu, D.; Jiang, X.; Ma, H.; Chen, Y. Fabrication of Partially Biobased Carbon Fibers from Novel Lignosulfonate–Acrylonitrile Copolymers. J. Mater. Sci. 2017, 52, 7439–7451. [Google Scholar] [CrossRef]
- Qu, W.; Bai, X. Thermal Treatment of Pyrolytic Lignin and Polyethylene Terephthalate toward Carbon Fiber Production. J. Appl. Polym. Sci. 2020, 137, 48843. [Google Scholar] [CrossRef]
- Enengl, C.; Lumetzberger, A.; Duchoslav, J.; Mardare, C.C.; Ploszczanski, L.; Rennhofer, H.; Unterweger, C.; Stifter, D.; Fürst, C. Influence of the Carbonization Temperature on the Properties of Carbon Fibers Based on Technical Softwood Kraft Lignin Blends. Carbon Trends 2021, 5, 100094. [Google Scholar] [CrossRef]
- Kim, M.S.; Lee, D.H.; Kim, C.H.; Lee, Y.J.; Hwang, J.Y.; Yang, C.-M.; Kim, Y.A.; Yang, K.S. Shell–Core Structured Carbon Fibers via Melt Spinning of Petroleum- and Wood-Processing Waste Blends. Carbon 2015, 85, 194–200. [Google Scholar] [CrossRef]




| Label | Lig | |||||||
|---|---|---|---|---|---|---|---|---|
| - | 120 | 250 | 280 | 285 | 295 | 1400 | ||
| 1 | LS | 120 | 255 | 280 | 280 | 295 | 1400 | |
| 2 | LS | 120 | 245 | 280 | 290 | 295 | 1400 | |
| 5 | LS | 120 | 255 | 270 | 290 | 295 | 1400 | |
| 10 | LS | 120 | 255 | 260 | 285 | 300 | 1400 | |
| 15 | LS | 120 | 250 | 270 | 280 | 290 | 1400 | |
| 20 | LS | 120 | 250 | 260 | 290 | 295 | 1400 | |
| 1 | AcL | 120 | 255 | 280 | 280 | 295 | 1400 | |
| 2 | AcL | 120 | 245 | 280 | 290 | 295 | 1400 | |
| 5 | AcL | 120 | 245 | 280 | 285 | 295 | 1400 | |
| 10 | AcL | 120 | 255 | 270 | 285 | 295 | 1400 | |
| 10 | AcL | 120 | 250 | 260 | 285 | 300 | 1400 |
Disclaimer/Publisher’s Note: The statements, opinions and data contained in all publications are solely those of the individual author(s) and contributor(s) and not of MDPI and/or the editor(s). MDPI and/or the editor(s) disclaim responsibility for any injury to people or property resulting from any ideas, methods, instructions or products referred to in the content. |
© 2024 by the authors. Licensee MDPI, Basel, Switzerland. This article is an open access article distributed under the terms and conditions of the Creative Commons Attribution (CC BY) license (https://creativecommons.org/licenses/by/4.0/).
Share and Cite
Wolz, D.S.J.; Seidel-Greiff, R.; Behnisch, T.; Kruppke, I.; Kuznik, I.; Bertram, P.; Jäger, H.; Gude, M.; Cherif, C. Potentials of Polyacrylonitrile Substitution by Lignin for Continuous Manufactured Lignin/Polyacrylonitrile-Blend-Based Carbon Fibers. Fibers 2024, 12, 50. https://doi.org/10.3390/fib12060050
Wolz DSJ, Seidel-Greiff R, Behnisch T, Kruppke I, Kuznik I, Bertram P, Jäger H, Gude M, Cherif C. Potentials of Polyacrylonitrile Substitution by Lignin for Continuous Manufactured Lignin/Polyacrylonitrile-Blend-Based Carbon Fibers. Fibers. 2024; 12(6):50. https://doi.org/10.3390/fib12060050
Chicago/Turabian StyleWolz, Daniel Sebastian Jens, Robert Seidel-Greiff, Thomas Behnisch, Iris Kruppke, Irina Kuznik, Paul Bertram, Hubert Jäger, Maik Gude, and Chokri Cherif. 2024. "Potentials of Polyacrylonitrile Substitution by Lignin for Continuous Manufactured Lignin/Polyacrylonitrile-Blend-Based Carbon Fibers" Fibers 12, no. 6: 50. https://doi.org/10.3390/fib12060050
APA StyleWolz, D. S. J., Seidel-Greiff, R., Behnisch, T., Kruppke, I., Kuznik, I., Bertram, P., Jäger, H., Gude, M., & Cherif, C. (2024). Potentials of Polyacrylonitrile Substitution by Lignin for Continuous Manufactured Lignin/Polyacrylonitrile-Blend-Based Carbon Fibers. Fibers, 12(6), 50. https://doi.org/10.3390/fib12060050

